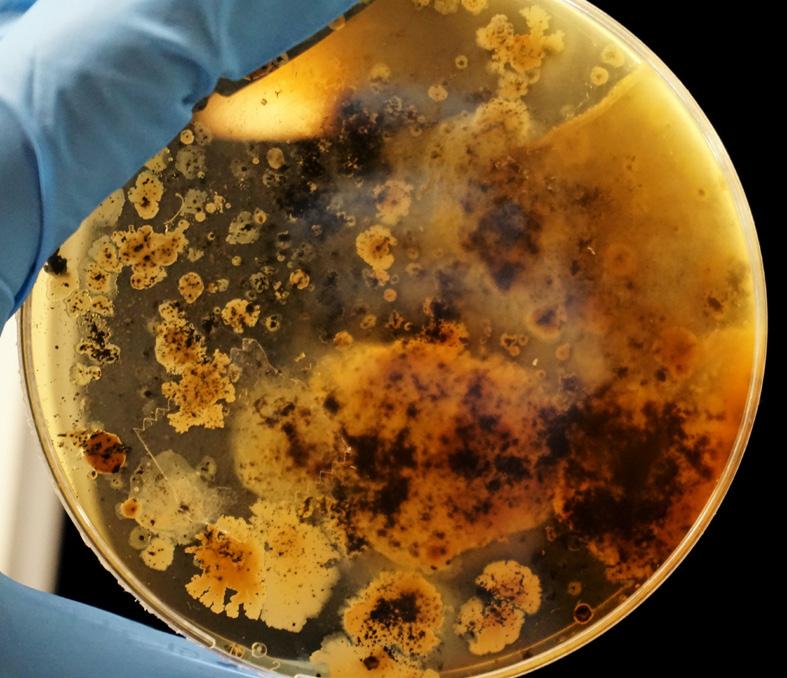

2 minute read
NHS proven disinfection system
THE Glosair is a simple machine which has been relied upon for over a decade by the NHS, to preventatively, or reactively, disinfect rooms up-to 2,000m3.
Building on that reliability, WASSENBURG Medical are proud to launch the new WASSENBURG Glosair®, which has been developed and improved in every way, and is now the ideal solution for managing Infection Prevention and Control in Care Home’s, too.
The new WASSENBURG Glosair® is a robust, fully self-contained machine which uses patented technology to disperse an environmentally friendly, biodegradable dry mist into the atmosphere; safely, effectively and economically eliminating all viruses, bacteria, fungi, yeasts, and spores. The odourless dry mist (Hydrogen
Peroxide Vapour) contains only 6% Hydrogen Peroxide, and Silver, eliminating COVID, C-DIFF and MRSA whilst achieving up to a LOG 6 reduction, with no residue, corrosion, allergens, or toxins.

We understand that protecting your residents, staff and visitors is your number one priority and that you want to be able to do this this as safely, reliably, and effectively as possible. The features and benefits of the WASSENBURG Glosair® support you in doing this.
It’s safe; uses RFID technology, securely and safely locking the chemical cartridges in place. Is manufactured to IS0 13485, despite not being a medical device. Comes with a remote control for added convenience and reassurance. Is an all-in-one, ‘1-plug’ system, minimising set-up and trip hazards. Has a simple appearance and is easy to use, empowering staff without making residents nervous.
It’s effective; with proven, validated efficacy conforming to EN17272. Provides 100% aerial and disinfection of all exposed surfaces, including even complex and out of reach areas. Is compatible with NHS encrypted USB’s, for recoverability and traceability of up to 200 treatments. Has optional testing kits, proving dispersion and efficacy, for accountability.
It’s efficient; 1 system, for most rooms. Is a whole room disinfection system, doesn’t tie-up staff. Has patented dispersion technology, for perfectly uniform dry mist coverage. Has an integrated fan, speeding up diffusion and degradation of the chemical. Is pre-programmable with up-to 20 rooms, taking seconds, saving hours. Is fully automated, ‘set-and-forget’, enabling staff to carry on working. Has 3 rubber castors, quick and easy to position in tight side-rooms. Has a 5m power cord, for convenience. Has a strong commercial grade body and handle, saving damage repair time.
It’s economical; incredibly good value for money compared to competitors, and uses only 1-7ml/ m³ flexible flow rate of chemical, resulting in zero waste and low ongoing running costs...
Why not give me a quick call now? And we can arrange a mutually convenient time for an on-site demonstration.
Parliamentary candidate pays Norwich care home a visit
MARY Chapman Court Care Home in Norwich welcomed Alice Macdonald, the Labour Party parliamentary candidate for Norwich North.

Alice, who was selected by the Labour Party last year to contest the Norwich North seat at the next general election, reached out to the Maria Mallaband Care Group run home to arrange the visit. She took a tour of the purpose-built facilities and an opportunity to meet







